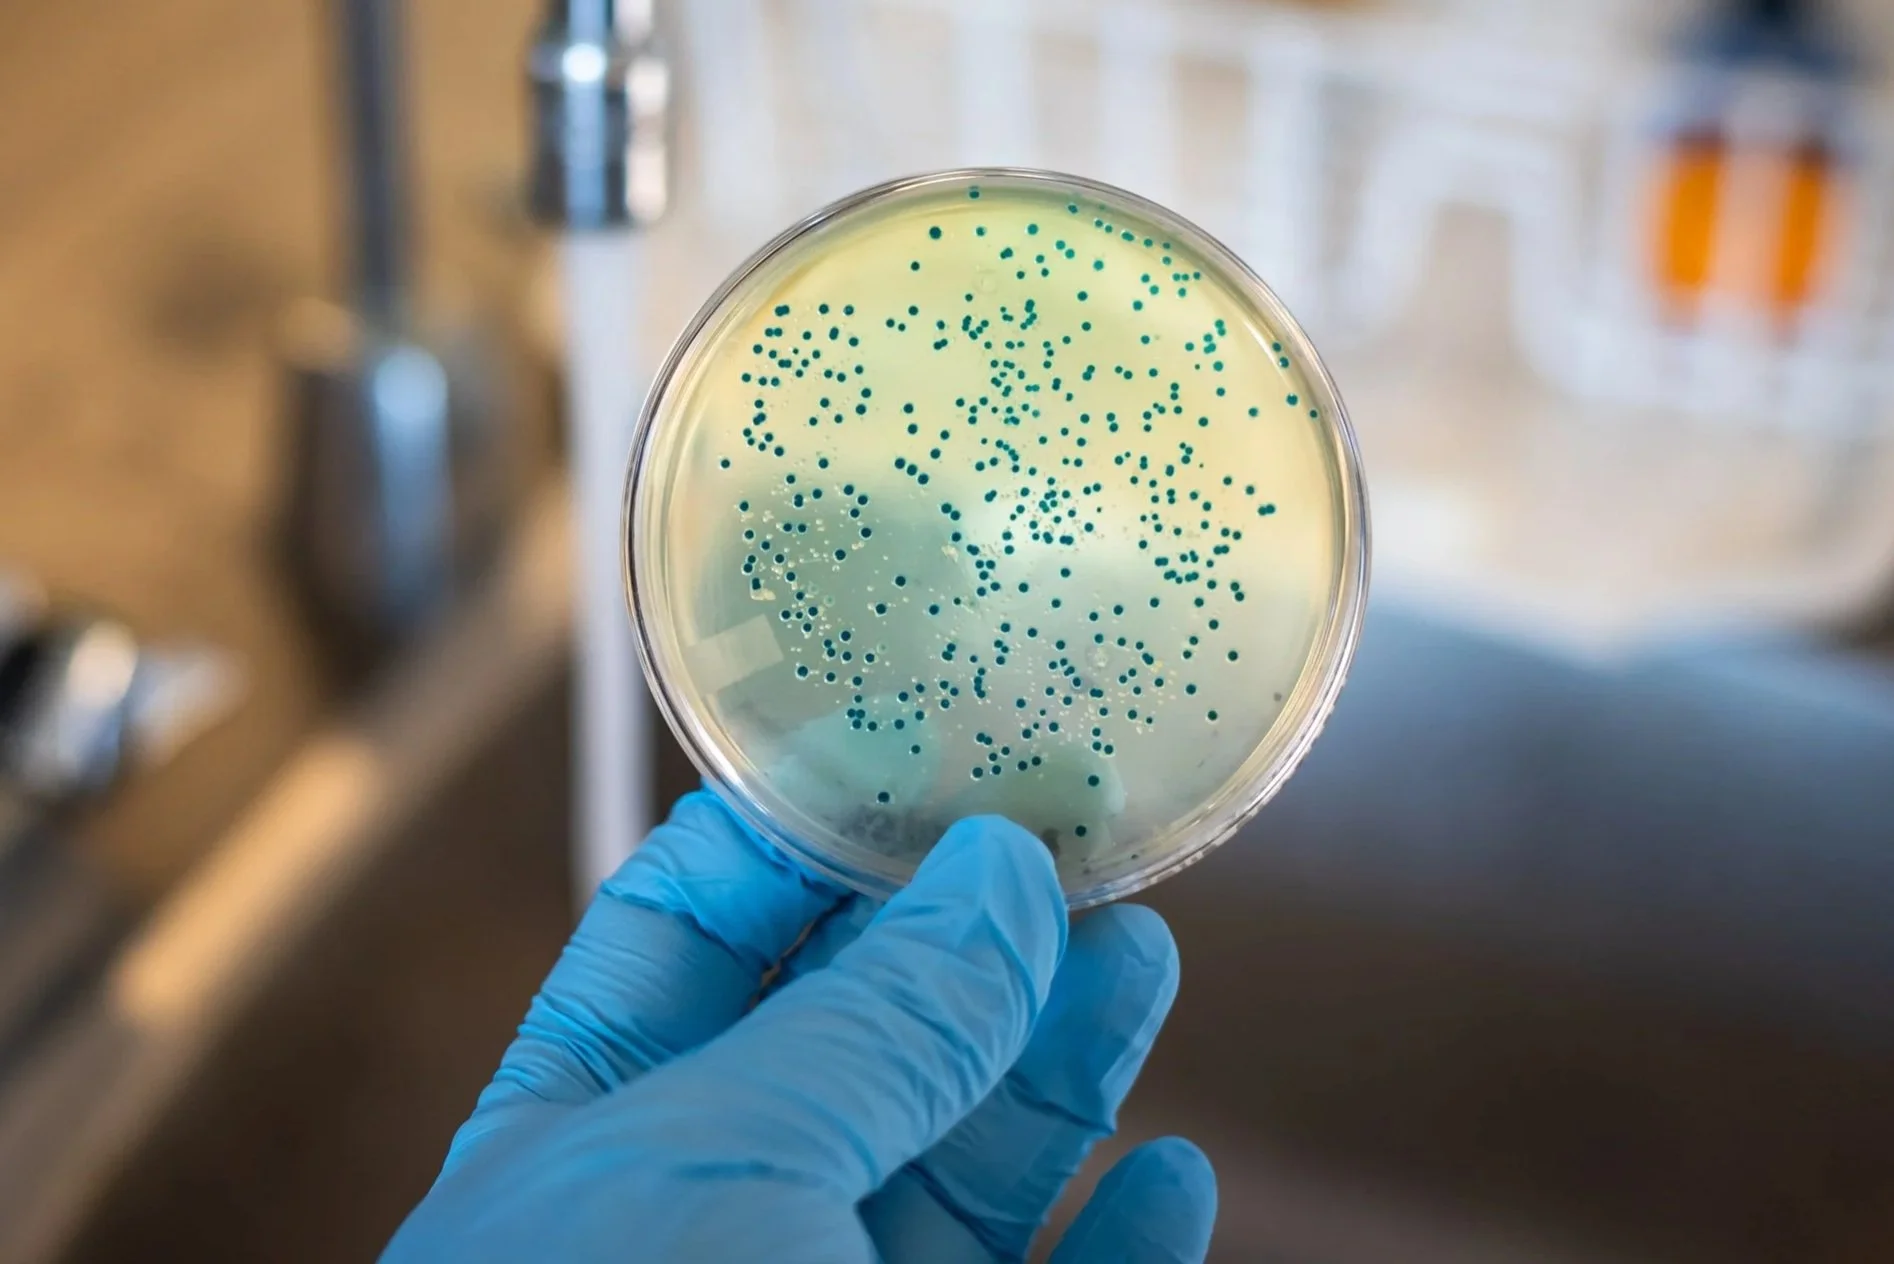

-

Mental Health Support for Rural Agriculture Workers
Rural agriculture workers experience high rates of depression, substance misuse disorders, and suicide. This initiative engages key community members — such as faith leaders, care providers, and extension agents — to promote greater access to behavioral health care.
-

Supporting the Well-Being of Workers in Small Businesses
This study examines how small organizations support the well-being of their workforce, how employees perceive workplace culture, and how to train small business owners. The findings underscore the importance of practical policies and programs to promote worker well-being.
-

Protecting Miners from Coal Mine Dust
Respirable coal mine dust can be inhaled deep into the lungs and is known to cause diseases such as pneumoconiosis, also known as black lung disease. This research uses innovative methods to expand what is known about this dust in order to better protect miners.
-

Heat Exposure for Agricultural Workers
Farmworkers are often at risk of overexposure to heat, which can cause serious health effects and even death. This project, created alongside agricultural workers, provides a multi-level approach to prevent heat illness, including training and resources for employers and workers.
-

Advancing Fall Protection in Firefighters
Slips, trips, and falls account for one-fourth of firefighter injuries annually. Engaging ~1,200 firefighters in many departments, this project aims to learn more about the causes of these injuries and devise strategies to prevent them.
-

Impact of Fatigue Among Mine Haulage Operators
Fatigue can decrease worker performance and reduce attentiveness, with major ramifications for safety in the mining industry. This research focuses on the impact, management, and prediction of fatigue among haulage operators, a crucial segment of workers in the industry.
-

Retrofitting Tractors with Rollover Protections
Rollbar-like devices called roll-over protective structures are 99% effective in preventing serious injury or death when tractors flip. By developing a computer app that creates designs for retrofitting older tractors, this project overcomes a hurdle in the adoption of these devices
-

Recovery Friendly Workplace Initiative
Supported by a bipartisan group of lawmakers, this initiative helps employers respond to substance use, mental health, and addiction in the workplace. Employers learn how to eliminate stigma and create work environments that support employee recovery and retention.
-

Beryllium and Its Effect on Worker Health
Exposure to beryllium, a strategic and critical metal for the defense sector, can cause an incurable lung disease. Years of research discovered that exposure levels were too high, leading both U.S. OSHA and DOE to improve protection policies that save an estimated 90 lives annually.
-

Insights into the Health and Safety of Loggers
By engaging hundreds of loggers through questionnaires and in-person health screenings, this project gathers valuable insight into cardiovascular risk factors, work-related injuries and illnesses, the prevalence of safety training, and other key issues affecting loggers.
-

Healthy Workplace Participatory Program Toolkit
Employers are increasingly understanding the value of a healthy and engaged workforce. This toolkit helps them build a culture of safety, health, and wellness by proactively engaging their employees in the process of solving their organization’s specific safety and health challenges.
-

Firefighter Cancer Initiative
Cancer is the No. 1 threat firefighters face, and this project provides free screenings for ~500 firefighters annually, in addition to research that equips fire departments, firefighters, medical professionals, and policymakers with the information they need to protect this workforce.
-

Protecting Farmworkers from the Bird Flu
The Highly Pathogenic Avian Influenza, or Bird Flu, is a significant concern in farm communities. Providing farmworkers, who face elevated risks, with up-to-date information, resources, and guidance is critical for ensuring they remain healthy.
-

Opioid Prescription Use Among Construction Workers
Construction workers are frequently prescribed opioids for the pain associated with work-related injuries, placing them at elevated risk of overuse, dependency, and overdose deaths. This project seeks evidence-based solutions to decrease opioid use among these workers.
-

Addressing Opioid Use Among Injured Workers
Injured workers who experience pain are among those at risk of misusing opioids. This project explores many dimensions of the issue, including effects of: opioid prescriptions on fatality rates, legal use issues in vehicle crashes, and how opioids impact overall health outcomes.
-

The Lifejackets for Fishermen Project
Lifejackets save lives — which is critical in the commercial fishing industry, where overboard-drowning deaths are tragically common. This project aims to increase lifejacket use among these workers by addressing barriers such as accessibility, cost, and social stigma.
-

Mental Health in the Construction Industry
In contrast to physical health and safety, few large-scale efforts have attempted to examine and improve the mental health of construction workers. This project bridges that gap, creating a multi-level suicide prevention and mental health promotion initiative for construction firms.
-

Examining Risks in the Poultry Processing Industry
Poultry workers are at risk of developing musculoskeletal disorders such as repetitive motion injuries. They may also be exposed to food processing chemicals. This study provides key insights on how employers can reduce risks in the poultry-processing industry.
-

Mental Health of Commercial Fishermen
Commercial fishing has a high suicide rate. There is a need to help hook up fishermen to mental health resources. This project uses an innovative approach, incorporating humor and relatable stories to encourage the use of mental healthcare resources and destigmatize seeking help.
-

Work Schedules and Firefighter Sleep, Health, and Safety
In response to trends that have significantly disrupted firefighters’ sleep — a known contributor to serious health problems — many fire departments are modifying shift structures. This research aims to determine whether these changes are improving health and safety outcomes.
-

Health Impact of Speed on the Meat Processing Line
Finding that many workers in swine-processing establishments are at high risk of musculoskeletal disorders and that the risk is associated with the speed at which they worked, this project provides insights for how these workers can be better protected.
-

Agricultural Safety Training Through Emergency Preparedness
Livestock handling injuries are common and are magnified during emergencies, such as wildfires, when ranchers must quickly relocate their livestock. This project aims to reduce these injuries through community emergency preparedness planning and training.
-

Well-Being and Cancer at Work (WeCanWork)
A cancer diagnosis can be life-changing, especially for those who want to keep working. This study assesses how cancer diagnoses affect the employment, financial health, and well-being of cancer survivors and improves patients’ workability, economic outcomes, and well-being.
-

Preventing Low Back Pain in Workers
Multiple research projects studying 2,700+ workers across many states are unearthing critical insights into preventing low back pain, one of the most common — and costly — musculoskeletal disorders affecting significant numbers of workers across industries.
-

Antibiotic-Resistant Bacteria in Livestock Operations
Livestock workers run the risk of becoming infected with antibiotic-resistant bacteria. This project is discovering antibiotic-resistant genes in manure that are identical to certain genes in common human pathogens, with implications for preventing hard-to-treat infections.
-

Boston Hospital Workers Health Study
Collaborating with two flagship hospitals that employ 40,000 workers, this project seeks insight into how workplace factors affect health, especially for low-wage workers. This project has major implications for the largest and fastest-growing sector of the U.S. economy.
-

Benefits of Exoskeletons in the Construction Industry
This research evaluates the benefits and barriers that construction workers face in using exoskeletons, finding that these wearable devices can enhance physical activity by providing mechanical assistance, reducing fatigue, and improving overall efficiency.
-
Farmworkers’ Exposure to Antibiotic-Resistant Bacteria
Antibiotic-resistant bacteria are a significant health concern in agriculture. Assessing the risks farmworkers face, including the most risky tasks, lays the groundwork for developing effective safety protocols to protect workers.
-

Emergency Preparedness for the School Workforce
This project involves the creation, implementation, and evaluation of a psychological preparedness training for the school workforce, including leadership and peer-support components. Teacher involvement improves current emergency preparedness plans and drills.
-

Harnessing Emerging Technologies to Reduce Risk of Biohazards
This collaboration aims to protect workers who encounter hazardous infectious agents by providing cutting-edge education in emerging technologies, developing workers’ real-world safety skills, and conducting innovative research to generate further advances.
-

Understanding the Opioid Epidemic in Agriculture
This project provides critical information regarding how the opioid epidemic is affecting agriculture and develops resources to help employers and workers navigate the many challenges associated with opioid use and misuse.
-

Supervising the Future of Remote Work
The rise of remote work has significant health-and-safety-related implications for both workers and their supervisors. This project provides training for supervisors of remote workers with the goal of boosting the well-being and productivity of both the managers and their employees.
-

Substance Use Awareness Among Commercial Fishermen
Substance abuse is a significant concern in the commercial fishing industry, yet in many places, there are limited resources to address it. This project seeks to protect fishermen in by raising awareness about substance use disorders and providing key resources.
-

Getting Injured Agriculture Workers Back to Work
Primary care physicians often lack expertise in workplace injuries yet are increasingly tasked with treating workers. This initiative educates physicians through a website featuring tools and resources to assist them in helping injured agriculture workers get healthy and return to work.
-

Screening Workers Exposed to Harmful Silica Dust
Workers exposed to silica dust, such as countertop fabricators, are at risk of silicosis, a severe lung disease that can lead to life-threatening complications. This project provides free medical screenings to such workers to identify problems early, years before symptoms may arise.
-

Slips, Trips, and Falls Among Fishermen
This project addresses the No. 1 cause of injury in the commercial fishing industry — slips, trips, and falls. It connects fishermen to primary care services and has engaged with nearly 300 fishermen to gain insights into the causes and prevention of these injuries.
-

Combatting a Leading Cause of Farm Deaths
Entanglements with a device that transfers mechanical power from a vehicle's engine to auxiliary equipment, known as a power take-off (PTO), are a leading cause of farm deaths. This project explores ways to successfully encourage farmers to adopt better safety protocols.
-
Backpack Hydration Systems For Farmworkers
Backpack hydration systems, widely used by the military and firefighters, offer a solution to dehydration and heat strain, which are key hazards in agriculture. This project evaluates the feasibility and practicality of integrating these systems on farms and other agricultural settings.
-

Protecting Healthcare Workers From Violence
Healthcare workers experience high levels of physical violence and threatening behaviors. This project finds that improvements in how incidents are reported help healthcare systems better identify risk factors and activate organizational responses to incidents of violence.
-

Reducing Back Pain for Lobstermen
With jobs that require reaching, lifting, and repetitive work, lobstermen often work in pain. Using “participatory ergonomics” — engaging the workers to design changes to their own work environment — improves work efficiency and reduces bodily strain and injury.
-

Safety and Health of Working Mothers
Working mothers face a distinct set of stressors that preliminary research links to symptoms like fatigue and chronic pain. This project digs into the issue, tracking working mothers’ heart data and exploring how it relates to their health and work experiences.
-

Impacts of Hypertension on Truck Driver Safety
In evaluating the impacts of high blood pressure on truck driver safety, including crash likelihood among drivers with hypertension, this research informs federal policy meant to protect truck drivers — and everyone else on America’s roads.
-

Worker Safety in the Cannabis Industry
The legalization of cannabis in many states has created thousands of jobs in an industry in which workers may face occupational health risks. This project is among the first to scientifically explore the hazards and potential health effects for workers involved in cannabis cultivation.
-

Thriving Workers, Thriving Workplaces
Ideally, people “thrive from work” — meaning their work and working conditions help create a fulfilled, positive mindset that extends into other parts of their lives. This project seeks to understand what fosters those experiences, key to helping as many workers as possible thrive.
-

Protecting People From The Spread Of Valley Fever
This project seeks to reduce the impact of Valley fever, a lung disease caused by a fungus found in outdoor dust in the West, by cautioning people when to avoid dusty conditions and alerting doctors when to expect more cases so they can quickly detect and treat the disease.
-

Protecting Outdoor Workers from Wildfire Smoke
Wildfire smoke is a health concern in many parts of the country for those who work outdoors, such as agricultural workers. Providing training and other resources for employers and workers regarding the health effects of wildfire smoke exposure and protection procedures is essential.
-

Health and Well-Being of Older Workers
By 2050, workers 55 and older are expected to make up one-quarter of the U.S. labor force. That makes this project’s aim of understanding the work-related factors that affect older workers’ health and well-being an issue of ever-increasing importance.
-

Medical Screenings for Federal Energy Workers
This project has improved thousands of lives by providing free medical screenings to 23,000+ former workers at federal energy laboratories and nuclear weapons facilities, identifying work-related conditions such as respiratory illnesses, hearing loss, kidney disease, and cancer.
-

Community Campaign to Reduce Farm-Vehicle Crashes
Fatal farm-vehicle crashes often occur on public roads and involve other drivers, such as when a car attempts a high-risk maneuver to pass a tractor. This campaign, called “We’re on This Road Together,” seeks to educate drivers about safe driving habits near farm vehicles.
-

Opioid Treatment and Work-Related Injuries
This project uses workers compensation records and data from a prescription drug monitoring program to examine the role and effects of opioids in workers who have physically demanding jobs in manufacturing, healthcare, and retail trade.
-

Robotics to Improve Mobility for Amputees, Stroke Victims
Wearable robotic devices are already reshaping the lives of millions of Americans, including those experiencing impairment, such as amputees and stroke victims. Among the devices under development: the Utah Bionic Leg, one of TIME magazine’s “Best Inventions of 2023.”
-

Reducing Tick-Borne Disease in Agricultural Workers
This project aims to reduce the risk of tick-borne disease for agricultural workers through 1) hosting informational sessions with these workers and 2) conducting a randomized control trial assessing the effectiveness of devices known as tick control tubes on farms.
-

Burnout in the Healthcare Industry
The COVID-19 pandemic compounded the already-serious problem of burnout among healthcare workers. Research-backed solutions like ones this project seeks to develop are needed to protect these workers as well as ensure high-quality care for the patients they serve.
-

An Economic Transition Pathway for Coal Country
Through economic and workforce analyses, this project provides a transition blueprint for a coal country region amid challenging economic circumstances spurred by declining coal production and planned closures of power plants.
-

Respiratory Protection for Dairy Workers
This project seeks to protect dairy workers at risk of potentially harmful agricultural dusts by testing the effectiveness of a nasal rinse that may prevent airway inflammation, a common condition in these workers.
-

Improving Mental Health in Farming Populations
Agricultural workers and their supervisors suffer from high rates of mental and behavioral health disorders, including anxiety, depression, and even suicide. This project assesses mental and behavioral health of workers in rural Colorado, identifying strategies to fill gaps in support.
-

Examining the Health and Safety of Truck Drivers
Multiple projects examining ~90,000 truck drivers are generating important findings regarding the health and safety of these workers, including a high rate of medical conditions, associations between specific health conditions and crash risk, and health trends over time.
-

Health and Safety of Gulf Seafood Workers
Many injuries and deaths in the commercial fishing industry are avoidable. This project includes research into the causes of injuries and deaths within specific industry subsectors and fosters collaborations with this workforce to promote safety knowledge and skills.
-

Oil and Gas Extraction Health and Safety Summit
This annual summit equips industry leaders, government officials, workers, and occupational health and safety professionals with state-of-the-art knowledge on key topics of interest, such as advances in heat stress protections, substance use in the oilfield, and silica exposure.
-

Zoonotic Disease Prevention for Veterinary Professionals
Workers in the veterinary profession are at risk for diseases that spread from animals to humans yet often don’t follow practices that can prevent transmission. In examining workers’ perceptions and habits, this project seeks ways to increase adherence to key safety measures.
-

Farm Safety for Rural Families Coping with Dementia
Older agricultural workers are at high risk of developing dementia. Those with the condition rely on family members to protect them from serious harm. This initiative provides family caregivers with training specific to agricultural settings on how to keep their loved ones safe.
-

Impact of Non-Traditional Work Arrangements on Well-Being
For many, work doesn’t look the same today as it did in the 20th century. A significant part of the workforce is engaging in “gig” work, freelance or contract work, and other alternative arrangements. Understanding how these types of employment affect well-being is critical.
-

Reducing the Spread of Infections in Healthcare Settings
Aerosols generated by patients with respiratory infections are a health hazard for healthcare workers and others near the patients. This study is developing a device for containing the aerosols and preventing the spread of infection.
-

Assessing Sleep Deprivation in Commercial Fishermen
This project involving fishermen in several states aims to better understand fishermen’s sleep patterns and the possible effects of sleep deprivation on their health and safety, a critical topic that has not been previously studied in depth.
-

Addressing Silicosis Among Countertop Fabricators
Workers who fabricate countertops using artificial stone are at risk of developing silicosis, an incurable and potentially fatal — yet preventable — lung disease. This project promotes respiratory health through education, medical monitoring, and enhanced surveillance.
-

Lung Health in Coffee Workers
Drinking coffee has been linked to health benefits, but the bean-roasting process produces a harmful chemical associated with a rare disease that can damage workers’ lungs. This project designs and tests a device to reduce exposure to the chemical, called diacetyl.
-

Chainsaw Safety Training for Loggers
Chainsaws are a major source of injury in the logging industry. By sponsoring training programs that include hands-on opportunities for loggers to practice what they learn, this initiative seeks to prevent these injuries.
-
Resilience and Recovery of Female Construction Workers
Though women are uncommon in the construction industry, more are entering the workforce. Examining the factors that affect female construction workers’ health and safety ensures that more women can join and succeed in the industry.
-

Promoting Safety in Small Construction Companies
Injuries and fatalities are common in the construction industry, yet there is no standard for safety education meetings, so-called “toolbox talks.” This project develops recommendations for small construction firms and aims to develop a standard for safety meetings for these companies.
-

Understanding Exposure to Harmful Dust in Dairies
Dairy farm workers may inhale bacteria, fungi, and viruses attached to dust particles, which can cause respiratory inflammation and asthma. This project examines the size and composition of the particles to generate insights into protecting workers from lung and allergic conditions.
-

Improving Well-Being of Public School Teachers
The challenging nature of public school teaching is well-documented. In partnership with teachers and schools, this project explores specific factors that affect teachers’ mental health and implements a well-being program tailored to educators.
-

Prevention of Upper-Extremity Disorders
Millions of workers across industries are at risk of upper-extremity disorders such as carpal tunnel syndrome, tennis elbow, and rotator cuff syndrome. Projects studying thousands of workers across many states are improving the ability to predict and prevent these disorders.
-

Protecting the Health of Youth Agricultural Workers
Minors make up a significant portion of the agricultural workforce in the U.S. This project protects them by providing free online education for the supervisors and managers who shoulder the direct responsibility for keeping young agricultural workers safe.
-

Health Improvement for Nursing Home Workers
Lifting and moving patients is a major contributor to low back injuries and other muscle and joint problems among nursing home workers. Programs meant to reduce the physical effort needed to move patients, including mechanical lifts, have proven effective in reducing these injuries.
-

The Role of Meetings in Promoting Creativity and Innovation
Building on two decades of research, this project examines how meetings can improve creativity and innovation within teams, with key implications for businesses and other organizations that aren’t reliant on complex problem-solving for success.
-

Understanding Chronic Kidney Disease in Farmworkers
Chronic kidney disease in farmworkers is a rapidly increasing concern, with evidence that exposure to pesticides and heat stress may play roles. Research exploring the links between those factors and kidney disease is crucial to understanding how to protect workers.
-

Implementation of Total Worker Health in Nursing Homes
Total Worker Health programs are intended to improve worker safety, health, and well-being, including in nursing homes. This project identifies what helps or hinders nursing homes from implementing programs, providing insights for researchers and decision-makers.
-

Improving Worker and Business Outcomes Via Better Meetings
More than half of the 55 million meetings in the U.S. each day are rated as poor. Bad meetings reduce engagement and increase burnout and turnover. The Center for Meeting Effectiveness works with businesses to improve meetings, worker well-being, and the bottom line.
-

Assessing Impact of Fatigue in Dairy Workers
This project examines how fatigue affects injury risk and work performance among those who work in dairy farms’ milking parlors. These workers have high rates of upper-extremity pain and often work long shifts performing repetitive, high-exertion tasks.
-
Health and Well-Being in Warehouse Fulfillment Centers
Warehouse fulfillment jobs are both physically taxing and mentally straining. This initiative evaluates the effectiveness of “health and well-being committees” in improving these workers’ mental health and reducing injuries.
-

Ergonomics Training for Small and Mid-Size Businesses
Work-related musculoskeletal disorders, such as low back injuries, are a major cause of disability and workers’ compensation claims across the U.S. Providing employers and workers with tailored resources to identify and control ergonomics risk factors reduces these disorders.
-

Empowering Fishermen to Improve Health and Safety
Workers in the commercial fishing industry face extraordinary health, safety, and well-being challenges. The development of a health and wellness pilot program provides these workers with a vital lifeline and paves the way for similar programs elsewhere in the U.S.
-

Tractor Driving Safety for Senior Farmers
Using a virtual reality tractor simulator that mimics real-life conditions, this project finds that aging farmers take longer to respond to dangerous situations. This discovery has significant safety implications given that serious tractor accidents can happen in fractions of a second.
-

Helping Home Care Workers Navigate Pain
A large percentage of home care workers suffer from chronic pain. This project provides resources to these workers to enhance their well-being and mitigate the progression of pain and common associated challenges, such as work-related disability and opioid misuse.
-

Ergonomics Improvements in the Dairy Industry
Musculoskeletal injuries commonly afflict dairy parlor workers. An ergonomics analysis is discovering ways of improving parlor space configuration and work station design to protect milking parlor workers.
-

Work Factors Influencing Health
Work-related factors such as how a worker’s job is structured, physical tasks they perform, and their organization’s culture impact their health. Developing a deeper understanding of these relationships informs policies and practices to improve workplace health and safety.
-

Respiratory Protection Program for Small Businesses
Intended for small businesses with limited resources, this program provides critical assistance related to respiratory protection, including fit-testing of respirators, assessments of risks to workers, and occupational health services.
-

Injuries and Deaths Among Farmers, Loggers, and Fishermen
The first step in protecting these workers is understanding the root causes of how they get hurt. This project improves tracking of injuries by applying advanced computer methods such as machine learning — a form of AI — to sift through large volumes of electronic health data.
-

Crisis Preparedness for Employers
Protecting workers in an emergency is an important consideration for employers before, during, and after an event. This project provides education that goes beyond the immediate impacts to risk mitigation before an emergency as well as post-disaster leave policies.
-

Improving Air Quality in Schools
Poor indoor air quality in schools is a growing concern, with implications for the health, comfort, and performance of both students and school employees. This project aims to improve air quality in schools through data-gathering, community engagement, education, and training.
-

Improving Safety in the Cattle Feedyard Industry
Beef cattle ranching and farming are highly dangerous lines of work, with fatality rates ~30 times higher than average. This project engages ranchers, farmers, and other stakeholders to develop an evidence-based health and safety program fit for wide implementation within the industry.
-

Improving Correctional Officer Safety and Health
The health and safety of correctional officers has not been significantly studied despite the stressful and often-hazardous nature of the job. This program addresses the urgent need for research that provides evidence-based ways to keep these workers safe and healthy.
-

Disaster-Preparedness Training
This program provides workers and others with disaster preparedness training. They gain skills in basic disaster response such as fire safety, light search and rescue, team organization, and disaster medical operations.
-

Risk of Diseases Spread From Swine to Humans
Workers who have regular contact with animals are at the front line of exposure to known and emerging pathogens. Tracking swine veterinarians over five years, this project is generating key data regarding their infection risks, such as MRSA, influenza A, and Hepatitis E.
-

Training Programs to Promote Worker Well-Being
Businesses are seeking ways to foster cultures where people feel valued and employee well-being is a core business strategy. These training programs are designed to help them do just that, providing executives with the tools they need to implement lasting change.
-

Training Workers How to Safely Handle Hazardous Materials
Many jobs require workers to handle hazardous substances and materials, from lead and asbestos to biological agents such as ricin. This training equips workers with the knowledge and practice they need to keep themselves, and others, safe.
-

Pesticides and Agriculture Workers’ Health
Agriculture workers are frequently exposed to toxic chemicals found in pesticides. This initiative is adding to the growing body of evidence regarding the dangers of long-term exposure to these chemicals and is generating resources to help protect these workers.
-

Leadership Toolkit for Labor-Intensive Industries
This initiative helps businesses in physically demanding industries build stronger leaders and safer worksites by equipping both management and crew members with tools, training, and support to address employee turnover, burnout, and inconsistent safety practices.
-

Support for Newly Hired Bus Drivers
This program improves the health, safety, and job performance of new bus drivers by providing enhanced training and support — including educating supervisors in ways to promote the well-being of their drivers.
-

Controlling Hazardous Dust and Gas in Livestock Buildings
Hazardous dust, gas, and bioaerosol concentrations are often high in livestock buildings, posing a risk to farmworkers. This project uses a novel technology, called a “mobile recirculating ventilation system,” to clear the air and ensure workers’ health and safety.
-

Nudging Towards Safety in the Dairy Farming Industry
The dairy industry has more injuries and deaths than any other type of farming. This project promotes affordable, easy-to-implement solutions. We often make decisions — including safety decisions — out of habit or convenience. This program “nudges” us to make safer choices.
-

How Seizures Affect Truck Safety
This research evaluates the impacts of seizures on truck driver safety with the aim of providing key insight to inform policy from the Federal Motor Carrier Safety Administration (FMCSA), which is responsible for regulating the U.S. trucking industry, including safety.
-
Engineering Controls to Reduce Rollover Deaths
Some tractor and mower operators may neglect to use cumbersome rollbar-like devices that are designed to prevent rollover injuries. This project aims to increase usage by simplifying the process of adjusting the bars.
-

Promoting Mental Health for Farmworkers
Agricultural workers face significant stressors that affect health and economic well-being. This program reduces mental health burdens in agriculture by connecting programs across the West to expand the volume and impact of resources and services available to farmworkers.
-

Reducing Health Risks for Firefighters
Firefighters are exposed to many harmful chemicals on the job, including flame retardants and other toxins that damage the brain and nervous system. Partnerships with large fire departments seek to gain insight into these risks firefighters face.
-

Addressing a Cause of Back Pain in Agriculture
Vibrating machinery can cause back pain in workers. This project generates key insights into body vibration when operating heavy machinery. Among the questions it seeks to answer is when seats need to be replaced and how seat suspension systems can minimize vibration.
-

Developing Sustainable Alternatives to Pesticides
There is a need for safe alternatives to many widely used, often toxic, pesticides. This project evaluates a process called “biosolarization,” which involves using solar heat to create soil conditions that are lethal to many pests and which could be financially viable for some farms.
-

From Hand Therapy To Human Factors And Ergonomics
Workers risk hand injuries when they grip tools, at a cost to workers and employers. Using cost-effective measurements of electrical signals in muscles, this research predicts ways to prevent injury.
-

Assessing and Preventing Injuries in Animal Agriculture
In addition to the human toll, injuries in the agriculture industry can have major economic consequences. By combining data regarding injuries, including workers' compensation claims, this project highlights financial incentives for stakeholders to work together to protect workers.
-

Preventing Heat Illness in Farmers
There is a need to educate farmers regarding the dangers of heat illness, which can turn fatal. This initiative provides training on topics such as the signs and symptoms of heat illness and how it affects health, practical ways to reduce risk, and explanations of worker rights.
-

Safety Management and Leadership in the Dairy Industry
A shift within the dairy industry toward a large-herd, mass-production model has led to a higher risk of injury and death in an already-hazardous industry. This project aims to reverse that trend by providing safety management and leadership training for frontline supervisors.
-

Agricultural Safety Education Initiative
Agricultural vehicles and machinery account for one-fourth of youth farmworker fatalities in the U.S. This initiative addresses that problem by training high school agriculture teachers in safety education and providing online resources to teachers nationwide.
-

Occupational Hazards in Pork Production
Injuries and exposures to harmful airborne contaminants are common when raising hogs. This project aims to determine how various farming practices affect the working environment and workers’ health and safety risks.
-

Tracking Injuries on Dairy Farms
Prior to this project, there was no good way to collect data on injuries in Wisconsin’s dairy industry. By establishing a database using surveys and health records, this project is generating key insights into dairy farm injuries and the best methods to prevent them.